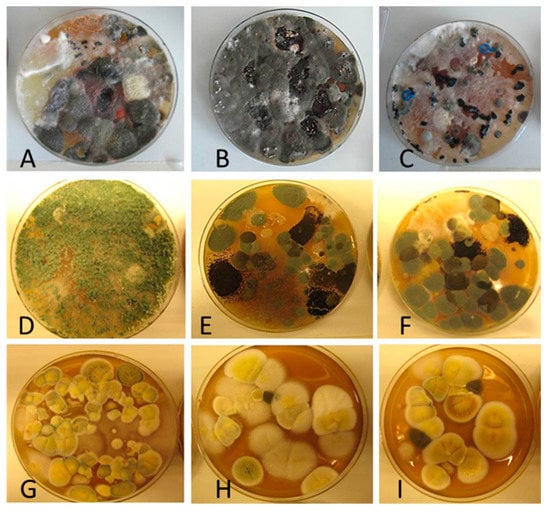

Abstract
This case study investigates the effects of ventilation intervention on measured and perceived indoor air quality (IAQ) in a repaired school where occupants reported IAQ problems. Occupants’ symptoms were suspected to be related to the impurities leaked indoors through the building envelope. The study’s aim was to determine whether a positive pressure of 5–7 Pa prevents the infiltration of harmful chemical and microbiological agents from structures, thus decreasing symptoms and discomfort. Ventilation intervention was conducted in a building section comprising 12 classrooms and was completed with IAQ measurements and occupants’ questionnaires. After intervention, the concentration of total volatile organic compounds (TVOC) and fine particulate matter (PM2.5) decreased, and occupants’ negative perceptions became more moderate compared to those for other parts of the building. The indoor mycobiota differed in species composition from the outdoor mycobiota, and changed remarkably with the intervention, indicating that some species may have emanated from an indoor source before the intervention.
1. Introduction
The success of moisture- and mold-damaged building repairs depends on many factors. Reaching a consensus about the necessary repair methods and schedule is not always simple, and the response to problems might therefore be delayed. Occupants’ symptoms and discomfort can have multiple causes, and detecting or treating them all is not always possible nor successful []. In cases where harmful impurities remain in the structures or crawlspaces after repairs, indoor air problems might still occur. It has been shown that negative pressure indoors may introduce harmful pollutants [], e.g., fungal spores [], which may cause adverse health effects among occupants []. Preventing infiltration of the possible impurities from the structures or surroundings, caused by high negative pressure, is crucial for maintaining a good indoor air quality (IAQ). In moisture damage repairs, a thorough renovation, including ventilation, is important [].
Ventilation is strongly associated with perceived IAQ, health, and productivity [,]. The chosen ventilation strategy also significantly affects the indoor microbial community []. Indoor fungi can be useful indicators of IAQ, therefore a deeper understanding of their biology is of special importance []. Ventilation, as well as indoor temperature and humidity, have a significant impact on human perceptions and well-being [,]. Proper ventilation measurements should be an essential part of every IAQ investigation []. In air-tight buildings with a mechanical ventilation system, the balancing and controlling of the ventilation system and pressure differences are inevitable []. When evaluating the effect of ventilation on perceived IAQ, pressure difference measurements are important [].
In cold-climate countries, keeping structures dry is a main issue, and ventilation design is strongly related to this objective. According to the National Building Code of Finland [], pressure conditions should not generate moisture loads on structures and, at the same time, not assist pollutant transfer through the structures. A ventilation design is typically balanced, or the extract airflow rate is slightly higher than the supply, to prevent exfiltration of moist indoor air into the structures. However, in well-ventilated buildings, the indoor air is often dry, and school buildings are typically occupied only during normal office hours. In such buildings, the risk for condensation is improbable despite the pressure conditions.
This ventilation intervention study was conducted as part of the Finnish EURA- and TOXICPM-research projects concerning IAQ and ventilation in renovated school buildings and microbial toxin transport mechanisms. The building discussed in this study has a history of moisture damage repairs, yet occupants still report IAQ-related symptoms and discomfort. The building is awaiting new major repairs. Our main hypothesis is that positive pressure differences across the building envelope could prevent the infiltration of harmful chemical and microbiological agents into the indoor air of damaged structures, thus decreasing occupants’ perceptions of symptoms and discomfort.
The aims of our research project were to determine the effects of significant ventilation system changes on measured and perceived IAQ in a school building with unsolved indoor air-related problems, and to provide information about the applicability of moderate positive pressure in a well-ventilated building awaiting repairs. To test the hypothesis, chemical, microbial, and physical IAQ measurements, as well as occupant questionnaires, were conducted before and after ventilation system intervention.
2. Materials and Methods
2.1. Building Characteristics
The study was carried out in a comprehensive school in Vantaa, Southern Finland. The school was selected in cooperation with Vantaa Real Estate Center in the spring of 2016, based on its repair history and the fact that a reasonable and controllable part of the building could be isolated for implementing the positive pressure intervention without major ventilation system changes in the building. According to Vantaa Real Estate Center, several microbial and structural investigations had been made since 2004, and the building had experienced extensive moisture damage, air leakage, and ventilation system repairs during previous years. Yet IAQ-related or unspecific complaints from the occupants had continued. New structural repairs to the whole building took place during 2017.
The school was built in 1968 and fully renovated in 2003–2005. Approximately 700 students and over 50 staff members worked in the building. The mechanical supply and extract ventilation system with heat recovery in all classrooms and corridors was installed in 2002. The building was connected to the district heating network and had central heating systems with water radiators and thermostatic valves. Each classroom had 2–3 supply air duct diffusers and 1–2 extract air grilles. Airflow rates were adjusted by dampers in the main air handling unit and with regulation and measuring devices connected to each terminal device. The studied section of the building as seen from the outside, and the typical supply and extract terminal units of a classroom in the section, are shown in Figure 1.

Figure 1.
Studied building section, a typical supply air duct diffuser, and an extract air grille in a classroom.
The studied part of the building consisted of 12 classrooms, one corridor, six toilets, and a cleaning storage area, and was served by one air handling unit. Most of the classrooms were occupied by 20–25 humans for a few hours per day during the normal five-day school week. The layout of the studied part of the building and its orientation are presented in Figure 2. Measurements were carried out in two classrooms located at different sides of the studied building part: Classrooms 3 and 9. According to the surveys conducted by the occupational safety and health personnel, occupants had reported the most severe IAQ problems in those two classrooms.

Figure 2.
The ventilation intervention was conducted in the building section marked with red. Measurements were carried out in Classrooms 3 and 9.
2.2. Previous Investigations
Due to the prolonged IAQ-related complaints in the building, an indoor climate and structural investigation (report 24 August 2016 handed over to the Real Estate Center of the City of Vantaa) was conducted in the whole building by a certified consultant company, Sweco Finland Oy (Helsinki, Finland), during April 2016 [], prior to this ventilation intervention research project.
In the base floor, tracer gas was used to detect the air flows possibly infiltrating from the ground. The air was found to infiltrate the room via wall/floor junctions and service entries, and the investigated classroom had negative pressure in relation to the ground filling. In outer wall tracer gas investigations, air leakages through the building envelope were found in the wall/floor junctions, window/wall junctions, and the supports for radiators and windowsills.
In the surface humidity detection of floorings, high humidity was detected widely in the studied building section, especially in the whole corridor area. During the cut measurement—where the flooring mat was cut and a relative humidity sensor was set under the flooring—the relative humidity (RH) under the flooring was normal, 28%, in Classroom 3. During drillhole measurements, a 16 mm hole was drilled to the concrete slab, measurement sensors were installed and sealed into the hole and read after stabilizing. High humidity was measured at all eight measurement spots (corridor and classrooms) with RH values between 87–95%. Nevertheless, simultaneous volatile organic compound (VOC) measurements in Classroom 3 did not show atypical material emissions referring to material deterioration (TVOC: 5 µg/m3, 2-ethyl-1-hexanol: 1 µg/m3). However, it was recommended that the surface flooring should be replaced with a more permeable material to avoid future problems.
In Classroom 3, the structures were opened for investigation. It was found that the outer wall structure did not follow the correct building design, i.e., the inner brick layer was covered by insulation and a vapor-tight concrete layer, which could lead to vapor condensation during the cold season. Material samples for microbiological analysis were taken from the structure’s opening. Microbial growth (fungi and bacteria) was found in the wooden structures of the window-frame fastening (Table 1). Actinobacteria and Exophiala * sp., which are indicators of moisture damage, were found in the mineral wool layer (Table 1). These findings verify the assumption that structures have been exposed to moisture and damaged because of incorrect building design. Microbial assessment of indoor air did not show increased microbial levels or moisture indicator microbes.

Table 1.
Microbial growth in outer wall structures of Classroom 3 [].
The investigation concluded that impurities from microbially damaged materials were possibly infiltrating indoor air, and might comprise a health risk. Infiltration is caused by air leakages and negative pressure, which is highest at night due to the continuously running extract air fans while supply air is shut down. Extensive structural repairs are needed in the lower parts of the outer wall to improve the building design as well as seal the air leakage routes.
2.3. Set-Up for Ventilation Intervention
The ventilation intervention was conducted in four phases: (a) airflow rates in the rooms were measured to determine the initial state of the ventilation; (b) the air distribution ductwork was fully balanced by an authorized company; (c) the air handling unit’s supply and extract fan speeds were adjusted to generate the desired 5–7 Pa positive pressure over the building envelope in each classroom; and (d) airflow rates in the rooms were re-measured, and pressure differences over the envelope were monitored during the entire set-up. Positive pressure across the exterior building envelope was maintained in the studied building section fairly well over the winter season, from August 2016 to May 2017.
The aim of generating low 5–7 Pa positive pressure was to prevent potential infiltration by harmful agents and avoid strong exfiltration of indoor air. In this ventilation intervention, it was possible to establish a positive pressure in the building by balancing the ventilation system and by adjusting fan speed control frequency in the air handling unit. The interzonal pressure differences of the studied building part were not measured, because the ventilation system was carefully balanced, and after the balancing all classrooms had practically the same supply and extract airflows eliminating potential pressure differences between classrooms. Each classroom had its own supply and extract air terminal units and classroom doors were typically kept close continuously, thus making the possible air mixing between rooms improbable.
Related IAQ measurements were conducted simultaneously with phases (a) and (d). Occupant perceptions were recorded, and microbial samples collected before the intervention and after five months of positive pressure. Moisture behavior of the structures during the positive pressure period was monitored, and will be reported in another journal article.
2.4. Measurement Methods
Some of the measurements were conducted in the entire building section under study; others were conducted in only the two classrooms with the most significant IAQ-related complaints from the occupants: Classrooms 3 and 9. The measured factors and measurement devices are presented in Table 2.

Table 2.
Measurement methods, devices and their accuracy, measurement place and duration.
2.4.1. Airflow Rate Measurements and Pressure Differences across the Building Envelope
Airflow rates were measured from each ventilation duct terminal unit in every room and in the corridor in the studied building section before and after balancing the ventilation, and after generating the positive pressure. Pressure differences across the building envelope were measured in Classrooms 3 and 9 continuously for one week before the ventilation intervention and for nine months after generating the positive pressure. A plastic tube with a copper core was placed outside by a window that was not normally open. A measurement device and a logger were placed inside near the window. The outdoor temperature was monitored simultaneously.
2.4.2. Temperature, Relative Humidity, and CO2 Concentration of Indoor Air
Temperature (T), Relative Humidity (RH), and CO2 concentrations were measured in Classrooms 3 and 9 for a one-week period before the ventilation intervention, and for a nine-month period after the intervention. Measurement devices were placed on the teacher’s desk in the front of the room, away from the teacher’s breathing zone when seated and as close to the horizontal central area of the room as possible.
2.4.3. Indoor Air Quality (IAQ) Measurements
VOCs were measured in Classrooms 3 and 9 and in the corridor before and after the ventilation intervention. TVOC and single compounds that had concentrations over 1 µg/m3 were analyzed. The VOC sampling and analyses were carried out according to ISO 16000-6 standard []. Air samples were taken from the central area of an empty, closed room, in the main working zone at a height of 1.5 m. Samples were collected in Markes International Ltd. (Llantrisant, UK) stainless steel tubes packed with Tenax TA (60/80 mesh) using GilAir Plus air sampling pumps (Sensidyne, St. Petersburg, FL, USA) at a flow rate of 200 mL/min for 40 min.
The samples were desorbed using a thermal desorption unit, TD-100 (Markes International Ltd.) and analyzed by a gas chromatograph, Clarus 580 (Perkin-Elmer Ltd., Beaconsfield, UK), equipped with a Clarus 600T (Perkin-Elmer Ltd.) mass selective detector. The VOCs were quantified by the scan (50–400 m/z) mode. Concentrations of TVOC and individual compounds were determined from TVOC area (n-hexane to n-hexadecane) and calculated as toluene equivalents. Concentrations of single compounds were also determined from the chromatogram before and after the TVOC area. In the case of such compounds, the quantitative result was indicative. Reference compounds and the NIST 2011 Mass Spectral Library automated mass spectral deconvolution and identification system (AMDIS) was used for identification. The detection limit was 0.2 µg/m3 (not included in sum concentration).
The formaldehyde concentration of indoor air was measured using an FM-801 formaldehyde meter (GrayWolf Sensing Solution, Sheldon, LA, USA), and carbon monoxide (CO) was measured with an electrochemical sensor with a TG-501 probe using an AdvancedSense meter (GrayWolf Sensing Solution). Fine particulate matter (PM2.5) was measured using a MIE pDR-1500 (Thermo Fisher Scientific, Franklin, MA, USA) nephelometer equipped with a PM2.5 size-selective inlet cyclone. Formaldehyde and PM2.5 were measured continuously for a one-week period before and after ventilation intervention, while CO was measured for a one-week period after the intervention. Measurements were conducted in Classroom 3, since only a single measurement device was available for these measurements.
Formaldehyde, CO, and PM2.5 measurement devices were placed in the back of the room, at a height of 1.5 m, as close to the central area of the room as possible. Inviolability of the devices had to be considered since the measurements were carried out for several days in a room occupied by children.
2.4.4. Characterization of the Mycobiota in the Indoor Dust
The mycobiota of indoor dust was collected from the studied building section’s extract air filter, as well as from the settled dust collected from Classrooms 3 and 9. Reference dust was collected from the outdoor air. Hay barn dust was also studied as a reference sample of rich, natural microbial environment. Characterization of the mycobiota was accomplished in three stages:
1. Sampling of dust from the extract air filter, air, and surfaces above floor level.
Material samples from the extract air filter were collected in sterile plastic bags. Pieces of the filter material (ca. 1 cm × 1 cm) were spread on malt extract agar (MEA) plates (Malt extract 15 g: Sharlab, Barcelona, Spain; agar 12 g: Amresco, Solon, OH, USA, in 500 mL of H2O). Dust samples were wiped into a clean plastic bag (Minigrip: Amerplast, Tampere, Finland) from ca. 30 × 30 cm2 surfaces 1–2 m above floor level. The dust (ca. 10 mg) was spread with a sterile cotton swab on MEA plates. Air samples were collected with MEA fallout plates that were kept open for an hour. Culture plates were inoculated, sealed, and cultivated at 22 °C for four weeks.
2. Rapid toxicity screening of single colonies with boar sperm and somatic cell lines.
For initial toxicity screening, 10–20 mg of biomass (wet weight) from each colony of the original culture plates was looped into 0.2 mL of ethanol and heated in a water bath for 10 min at 80 °C. The obtained ethanolic lysates were exposed to porcine spermatozoa and kidney tubular epithelial cells (PK-15, Finnish Food Safety Authority, EVIRA, Helsinki, Finland). The lysate was considered toxic when 2.5 vol % decreased boar sperm motility, or 5 vol % decreased proliferation of PK-15 cells by >50% compared to the sham exposed control. Boar sperm motility inhibition assay (BSMI) measuring motility inhibition (i.e., inability to respond to induction of motility in resting sperm cells exposed for one day at room temperature) is described in []. The inhibition of cell proliferation (ICP) assay with PK-15 cells and the determination of EC50 concentrations followed the methods described by []. The colonies that displayed toxicity were streaked pure and identified to genus or species level.
3. Characterization and identification of the fungal isolates.
Fungal colonies were grouped into 12 morphotypes based on colony morphology on MEA, ability to grow at 37 °C, light microscopy of the conidia and conidiophores, and responses in the two toxicity assays, BMSI and ICP. The isolates were compared to the identified strains from our strain collection, HAMBI, or identified according to []. Representatives for the morphotypes were identified according to their ITS sequences [].
2.4.5. Indoor Air Questionnaire
Occupants’ indoor air-related symptoms and discomfort were recorded with the standardized Indoor Air Questionnaire of the Finnish Institute of Occupational Health (FIOH) twice during the research. The questionnaire was based on the Örebro Indoor Climate Questionnaire MM40 [].
The questionnaire consists of four different foci: (1) the work environment; (2) the work arrangements; (3) the employees’ allergy history; and (4) work-related symptoms. The questionnaire asked the respondents to recall environmental problems (draft, dry or stuffy air, etc.) that had occurred during the past three months.
Staff members of the whole school were requested to participate in the questionnaire, and the principal of the school arranged for the delivery of the questionnaires at the workplace. Staff members had two weeks to respond to the questionnaire. FIOH collected and reported the answers.
Potentially significant differences between the two questionnaires were analyzed at Aalto University by the SPSS statistical software (SPSS Finland Oy, Espoo, Finland), with a chi-squared test. The main interest was to determine whether symptoms supposedly related to impurities from the structures could be reduced by converting infiltration to exfiltration in the studied building section.
3. Results and Discussion
3.1. Airflow Rate Measurements and Pressure Differences across the Building Envelope
Total airflow rates before and after the ventilation intervention are shown in Table 3.

Table 3.
Supply and extract airflow rates of the studied building section before ventilation balancing, after balancing, and after generating positive pressure.
Before balancing, the airflow rates were found to be heavily unbalanced in most classrooms, as well as in the corridor and in the toilets (Table 3). According to Finnish regulations, the acceptable deviation at room level and system level is 20% and 10%, respectively. At classroom level, the supply airflow rates were within ±20% of the designed values, with two significant exceptions of −36% (Classroom 7) and +57% (Classroom 8). Almost all the classrooms had extract airflow rates over 20% higher than the designed values. The corridor extract was 18% lower than the designed values. The extracts from the toilet and storage units were 55% lower than the designed values, which was found to be caused by the wrong rotation direction of the fan. At a system level, the total extract airflow rate was 18% higher than the designed values. After generating the positive pressure, all classrooms except from Classrooms 4 and 8 received more supply than extract air. Airflow rates were measured as spot checks from some classrooms in spring 2017, and had been maintained at the required level.
Pressure differences across the building envelope from one week before and after the intervention in Classrooms 3 and 9 are shown in Figure 3.

Figure 3.
One-week pressure difference across the building envelope in Classrooms 3 and 9 before and after the ventilation intervention. In Classroom 3, the results before intervention were recorded only for half of the week because of dysfunction of the measurement device.
Before the ventilation balancing, pressure differences fluctuated within a large range during a one-week period, and both measured rooms had a significant level of negative pressure. After the ventilation balancing, the pressure differences across the envelope were moderately stable and positive, and fluctuation was minimal compared to the conditions before the intervention (Figure 3). Pressure differences over the entire ventilation intervention period are shown as cumulative frequency curves (duration curves) in Figure 4.

Figure 4.
Duration of pressure differences across the envelope in Classrooms 3 and 9 during nine months after ventilation intervention.
Positive pressure was maintained rather well in Classroom 9, but poorly in Classroom 3 (Figure 4). In Classroom 9, the pressure difference was at the optimal level of 5–7 Pa for 23% of the measurement time, and over 0 Pa for 84% of the time. In Classroom 3, it was over 0 Pa for 45% of the time; thus, most of the time, Classroom 3 had a pressure difference very close to 0.
According to the set-up design, positive pressure should have been maintained continuously throughout the entire intervention period. However, the results showed that the ventilation system was turned off at night by the school maintenance or by the automatic remote-control system during school holidays; it was also turned off during other short-term periods for unknown reasons. The longest holiday period was the Christmas holiday, between 21 December 2016 and 7 January 2017, during which time the ventilation system was clearly turned off every day from 4 p.m. to 6 a.m., and the pressure difference became highly negative. Negative pressure differences during that period were significant (up to −18 and −22 Pa in Classrooms 3 and 9; average pressure difference −7.9 and −8.4 Pa), generating unwanted effects on the ventilation intervention.
The building was unoccupied during holiday periods; thus, pressure fluctuation did not have a direct impact on the occupants. Furthermore, if the Christmas holiday period is ignored, then the pressure difference becomes positive (>0) for 46% (Classroom 3) and 88% (Classroom 9) of the time, which does not make a significant difference to the duration of the pressure difference on a longer period of time. However, possible impurities inside the structures may have infiltrated indoors during holiday periods, which would have influenced the indoor conditions and might have affected the user questionnaire responses accordingly. Therefore, holiday times, especially the Christmas holiday, were not excluded from the data.
The measured results show an increase of positive pressure when the outdoor temperature increases (Figure 5), and a corresponding decrease when the outdoor temperature drops. This has provided an additional challenge for positive pressure as adjustments were done during warm season. These results indicate typical phenomena of heat recovery ventilation units: During the cold season, the mass flow of constant volume extract fans becomes higher because the temperature after heat recovery is lower and the density of the air is correspondingly higher. At the same time, the supply air fan operates at stable air temperature conditions and the mass flow does not change. To avoid this phenomenon, an air handling unit with density-corrected air volume flow rate control should be used to maintain a continuous positive pressure in a building.

Figure 5.
Relation between outdoor temperature and pressure difference across the envelope in Classrooms 3 and 9 with air handling unit without density-corrected airflow rates.
In a cold climate, water vapor condensation and moisture accumulation inside structures are seen as potential risks when pressure differences across the envelope are positive. To evaluate the risk of condensation inside the structures, excessive moisture in Classrooms 3 and 9 was calculated as the difference of measured absolute humidity of indoor and outdoor air, before the positive pressure period began. To monitor the possible moisture condensation risk in the structures during the ventilation intervention, T and RH probes were installed inside the structures at the most probable leakage paths, as well as in a reference room. According to humidity measurements, the structures were dry, indicating that this moisture risk was not present because of the modest humidity load in well-ventilated classrooms [].
3.2. Temperature, Relative Humidity, and CO2 Concentration of Indoor Air
Results from one week before and after ventilation intervention are shown in Figure 6.

Figure 6.
Temperature, relative humidity, and CO2 concentration in Classrooms 3 and 9 one week before and after the ventilation intervention.
The measurement results after the ventilation intervention are shown as a duration curve in Figure 7, and average, minimum, and maximum values are described in Table 4. Only results during school working hours, from 8 a.m. to 5 p.m., are shown to describe conditions during occupancy.

Figure 7.
CO2 concentration, relative humidity, and temperature duration in Classrooms 3 and 9 during school’s occupancy hours, from 8 a.m. to 5 p.m. on Monday–Friday, measured continuously from 24 August 2016 to 9 May 2017 after ventilation intervention was conducted.

Table 4.
Relative humidity, temperature, and CO2 in Classrooms 3 and 9 during school’s occupancy hours, from 8 a.m. to 5 p.m. on Monday–Friday, between 24 August 2016 and 9 May 2017.
The maximum limit value for CO2 concentrations in Category I of the Finnish Classification [] is 750 ppm; the limit value in Category II is 900 ppm, while in Category III it is 1200 ppm. The stability of the conditions has to be 95% (Category I) and 90% (Category II). Category III meets the minimum requirements of the Finnish regulation, Category II is defined as good and Category I as best possible IAQ. The levels of CO2 concentrations before and after the intervention were in Category I (Figure 7 and Table 4).
The RH of the classrooms closely followed the absolute humidity of the outdoor air, i.e., values are very low in cold winters and reach 75% on summer days. In Category I [], it is recommended that RH should not drop for long periods below 20%; no recommendations exist for the other categories. It can be seen in Classrooms 9 and 3 that RH was below 20% for 31% and 26% of the school hours, respectively (Figure 7). Such dry air causes irritation of the respiratory tract, eyes, and skin []. Indirectly, temperature and RH affect human perceptions of air quality and emissions from building materials [,,] with negative effects associated to higher temperature and RH values. From this point of view, there are some arguments for humidification during cold winter time, but as far as Category II spaces are considered, it is not needed. Contra argument to humidification is to keep the ventilation systems simple and not equipped with humidification components due to cost, hygienic and maintenance issues.
Temperatures were very stable and slightly higher in Classroom 9 (Table 4), which can be explained by the location of the room on the western side of the building.
3.3. Indoor Air Quality (IAQ) Measurements
TVOC, VOC, formaldehyde, and CO measurement results are shown in Table 5.

Table 5.
TVOC, VOCs (concentrations over 1 µg/m3), formaldehyde, and CO before (a) and after (b) ventilation intervention.
TVOC values decreased 21–55% in the classrooms and in the corridor after ventilation intervention (Table 5). This result was statistically significant at a 95% confidence interval (p = 0.045). Besides positive pressure, no other changes were undertaken; therefore, the only known explanation for the decreased concentrations is the positive pressure and infiltration mainly converted to exfiltration. Concentrations were very low in general, compared to the national threshold values [], indicating good ventilation and off-gassing of materials.
Concentrations of single VOCs were 1–4 μg/m3, which is fairly below action level. TVOC concentrations consist mainly of compounds with concentrations below 1 µg/m3. In addition to the general limit value for single compounds, national limit values for the following VOCs are 2,2,4-trimethyl-1,3-pentanediol di-isobutyrate (TXIB) (10 µg/m3), 2E1H (10 µg/m3), naphthalene (10 µg/m3), and styrene (40 µg/m3) []. In these samples, only 2E1H was shown, but only as low concentrations from 1 to 3 µg/m3 (Table 5).
For formaldehyde, the maximum allowed value is 50 (annual average) or 100 µg/m3 (30 min average), while for CO it is 7 mg/m2 (momentary concentration) []. The formaldehyde concentration before and after the ventilation balancing was below 10 ppb (equivalent to approx. 12 µg/m3), which is the detection limit of the meter. After balancing, there was a concentration of 12–26 ppb during two hours on one day, which was probably due to some specific action in the classroom, e.g., art lecture. The CO concentration varied from 0.3 to 1.3 mg/m2.
Particulate matter 2.5 µm measurement results are presented as a duration curve in Figure 8, and parameters for statistical analysis are given in Table 6.

Figure 8.
Duration curves of particulate matter 2.5 µm before and after the ventilation intervention in Classroom 3 during one week.

Table 6.
PM2.5 concentrations in Classroom 3 before and after the ventilation intervention: Statistical parameters.
The limit value for the PM2.5 mean concentration following 24 h in indoor air is 25 µg/m3 []. All known PM2.5 sources in the studied building are outdoor sources; for example, traffic and burning products. PM2.5 concentrations were very low before and after the intervention (Figure 8). However, tested by the independent two-sample t-test (Table 6), the difference in medians was statistically extremely significant at the 100% confidence interval (p = 0.000, 2-tailed). Daily actions can affect the PM2.5 concentrations temporarily; but due to the one-week measurement time, the results are reliable and show a clear correlation with the positive pressure.
3.4. Characterization of the Mycobiota in the Indoor Dust
Diversity and the pathogenic and toxigenic potential of the mycobiota cultivable from indoor dust were characterized. Dust from extract filters and surfaces above floor levels were sampled and cultivated before and after the ventilation intervention. Outdoor dust and air were sampled as references. The fungal colonies are shown in Figure 9.
Figure 9.
Fungal colonies sampled from the outdoor air and from the extract air filter dust before and after the ventilation intervention. The outdoor air and dust contained black Curvularia-like colonies (A–C). Extract air filter sampled before the ventilation intervention contained green Trichoderma colonies (D), and green Penicillium and black Aspergillus colonies (E,F). Extract air filter sampled after the ventilation intervention contained yellow Penicillium colonies and yellow Aspergillus colonies (G–I).
The fungal colonies representing the dominant morphotypes after four weeks of incubation were characterized to genus or species level (Table 7). The results in Table 8 show that Rhizopus sp. strains unable to grow at 37 °C were the most commonly isolated fungi in filter dust and settled dust collected before and after ventilation intervention. The results also show that toxigenic, potentially mycoparasitic Trichoderma atroviride strains represented the dominant morphotype, as shown in Figure 9D, on the three plates in both extract filter dust and settled dust collected before the ventilation intervention (Table 8). The dominant morphotypes in this dust contained potentially pathogenic Aspergillus and toxigenic Penicillium species.

Table 7.
The twelve morphotypes representing the dominant fungal genera and species isolated from the extract filter, settled dust and outdoor air.

Table 8.
Cultivable mycobiota in indoor dust from the extract air filter and from classroom surfaces above the floor level. The dust was sampled before and after the ventilation intervention. Names in brackets indicate the presence of a single colony on a single plate.
In dust collected after the ventilation intervention, the dominant mycobiota (except Rhizopus sp.) consisted mainly of nontoxigenic Penicillium strains and toxigenic Aspergillus species unable to grow at 37 °C (Table 8). One toxigenic Trichoderma longibrachiatum strain able to grow at 37 °C, one toxigenic T. trixiae and one toxigenic Penicillium expansum colony were found on one plate each. Reference samples collected outside of the school contained toxigenic Curvularia sp.—like colonies, rendering these outdoor samples the highest number of toxigenic colonies. The hay barn dust did not contain toxigenic species or potentially pathogenic Aspergillus strains. The indoor mycobiota differed in species composition from the outdoor one, and changed simultaneously with the ventilation intervention. Interestingly, no mycoparasitic Trichoderma atroviride strains were cultivable from the outdoor samples or barn dust. This indicates that this species, isolated from the extract filter and settled dust before the ventilation intervention, may have emanated from an indoor source.
It should be noted that the dust collected from the extract air filter represents the air collected from the studied building part during a several months’ period of time, thus being an exceptionally encompassing sample. However, the filter may have been impacted also by outdoor air if the classroom windows have been kept open, which needs to be considered when assessing the representativeness of the results for indoor air of a given building.
3.5. Indoor Air Questionnaire
Indoor air questionnaire results from the studied building section and from the other building sections are presented in Table 9. Occupants answered the questionnaire in the studied building section before the ventilation intervention (May 2016) and after the intervention (January 2017), as well as simultaneously in the other building sections where no ventilation or other changes had taken place. Because of the low amount of data, Fisher’s exact test was used in the statistical analysis of several factors instead of the chi-squared test.

Table 9.
Indoor climate questionnaire (Finnish Institute of Occupational Health© 2006–2008, version 2.0) results from spring 2016 and winter 2017. Statistically significant changes at a 10% confidence interval (p < 0.1) are bolded. p-values marked with * were determined by the Fisher’s exact test (SPSS). Comparison values are based on the analysis of comprehensive questionnaire data collected by FIOH.
In the studied building section, the known changes in the conditions between the 2016 and 2017 questionnaires were outdoor conditions (seasons) and the ventilation intervention. In other building sections, the only known change was the season. Also, psychosocial factors have an impact on perceptions []. In the studied building section, conclusions about the effect of psychosocial factors on IAQ perceptions could not be drawn compared to other building parts.
The first questionnaire (May 2016) was conducted during the spring when pollen may increase the symptoms of allergic diseases and thus effect the perception of indoor climate; however, the air handling unit had effective fine F7 class filters. The second questionnaire (January 2017) was conducted during the winter when the indoor air was very dry because of the low absolute humidity of the outdoor air. Dry air typically increases the prevalence of cough, nose and eye irritation, and skin symptoms []. Mechanical ventilation is shown to increase symptom prevalence, related especially to air dryness [,,]. The impact of the season (spring/winter) can be seen from the results of other parts of the school that were not under intervention.
Due to the low number of occupants and the low response rate (58% and 62%) in the studied building section, individual answers were emphasized and significant differences (p-value < 0.05) were mostly not found in the statistical analysis (Table 9). The unwanted negative pressure differences, especially during holidays, might have affected indoor conditions and occupants’ perceptions. Between 2016 and 2017, the prevalence of hoarse, dry throat (p = 0.118), heavy-feeling head (p = 0.183), cough (p = 0.321), and headache, as well as difficulties concentrating (p = 0.444), increased. Also, the prevalence of varying temperature (p = 0.162), draft (p = 0.275), and insufficient ventilation (p = 0.372) increased.
However, when comparing the changes in the studied building section to changes in the other building sections, a different trend emerged. The perception of low temperature (p = 0.345), stuffy air (p = 0.085), dry air (p = 0.103), and visible dust (p = 0.408) increased between 2016 and 2017 in other building sections; however, the increase was not statistically significant. This can be explained by seasonal changes. However, in the studied building section, no worsening in the same factors (p = 1.000) was reported.
A decrease in the perceptions of too high temperature (p = 0.477) was reported in the studied building section, while in other sections the number of perceptions was already very low in the first place. Perception of unpleasant odor decreased (p = 0.638) in the studied section to the same level as it was in the other sections. An increase in the perception of draft (p = 0.275, p = 0.253) and insufficient ventilation (p = 0.342, p = 0.352) was reported correspondingly in both sectors.
In the other building sections, tiredness (p = 0.077), nose irritation (p = 0.085) and dryness of facial skin (p = 0.036) increased, while no change in the studied section was seen (p = 1.000). The same tendency was seen in the factors which were statistically not significant, i.e., hand skin symptoms (p = 0.352) and shortness of breath (p = 0.491) increased as well. This is an interesting result considering that, simultaneously, reported asthma decreased (p = 0.253) in the other sections but not in the studied section. In addition, the prevalence of hay fever increased (p = 0.188) in the studied section, and the perceptions of heavy-feeling head (p = 0.183) and cough (p = 0.381) also increased more than in the other sections (p = 0.706 for both).
It can be concluded that IAQ in the building was perceived as being worse more frequently in 2017. In the studied building section, major improvements in occupants’ perceptions were not reported; however, neither was reported significant worsening in many of the factors that worsened in the other building parts during the follow-up time.
4. Conclusions
Ventilation is an essential part of indoor environment quality. As shown in this study, even relatively small changes in air flow rates and pressure differences can have noticeable effects on the measurable and perceivable parameters of indoor air. CO2 concentration is often highlighted as an indicator of sufficient ventilation rate, but should never be used alone to determine the state of ventilation in an indoor space. In the studied building, CO2 measurements alone would have indicated good IAQ and sufficient ventilation. In order to study IAQ and occupants’ well-being in an indoor space, a holistic ventilation investigation was revealed to be essential.
The aim of 5–7 Pa positive pressure for a period of nine months was only partly reached. In another studied classroom, the pressure difference was mostly close to 0 Pa. The TVOC and PM2.5 concentrations decreased significantly after ventilation intervention, yet these were initially very low.
The occupant questionnaire data analysis suffered on the small sample typical for this kind of study and statistically significant improvements were mostly not demonstrated. The results were, however, analyzed to determine possible differences between the studied building section and the other parts of the building, where no actions were taken. In the follow-up questionnaire conducted after five months of positive pressure, the occupants’ perceptions had worsened more moderately, if at all, compared to the occupants’ perceptions in the other building sections, where perceptions had worsened significantly and the only known change in conditions was the season. Seasonal effects on human perceptions were significant due to the cold and dry air of the winter, and also likely due to psychosocial aspects, e.g., darkness during the winter. This effect can be seen in the questionnaire data from the other building sections, but not as clearly in the data from the studied building section. This indicates that positive pressure could be a practical way to decrease perceived IAQ-related problems, but research with a larger occupant sample and studying the same season during the follow-up are needed to confirm this indication.
This study also shows that the change in pressure conditions coincided with a partial but important change in species composition of the indoor microbiome: The potentially pathogenic species of Aspergillus able to grow at 37 °C (Aspergillus section Nigri and section Flavi strains) were replaced with Aspergillus strains unable to grow at 37 °C (Asp. westerdijkiae and Asp. versicolor-like strains). There are only a few Aspergillus species that frequently cause infections in humans: A. fumigatus and A. niger which are responsible for more than 90% of systemic and lung infections whereas A. flavus is the main cause of eye infections []. The occurrence of potentially pathogenic isolates of Paecilomyces and Trichoderma species are of concern. However, these strains seem to be minor representatives of the viable mycobiota.
The occurrence of potentially mycoparasitic T. atroviride strains disappeared after the intervention. The small-sized conidia (<4 µm) of T. atroviride, Aspergillus, and Penicillium species from extract filters collected under negative pressure differences may represent viable fungi emanating from building constructions, as fungal spore penetration in indoor spaces under negative pressure has previously been shown.
The new method used for microbial sampling is proposed for wider testing. In this method, microbes were collected from the extract air filters as representatives of the microbiome within full building and its constructions, which are potentially and occasionally liberated into indoor air due to fluctuations in pressure differences across the building envelope. According to this study, this method could be a relevant way to investigate sources of impurities in buildings with indoor air problems.
This study indicates that by ventilation interventions, conditions in a building with unsolved IAQ problems or awaiting repairs can be controlled without other major temporary actions. Positive pressure could be efficient, especially in a building with microbial damage or other impurities infiltrating from the structures. When utilizing positive pressure, the pressure difference should be high enough to constantly cover all spaces and the variation in ventilation. Potential excess moisture indoors must be low or controlled by ventilation to prevent condensation inside the structures.
Acknowledgments
The authors warmly acknowledge the Academy of Finland (grant TOXICPM 289161), the Finnish Work Environment Fund (grant EURA 115376) and Tekes (grant 4098/31/2015) for funding this research. The participation of the Real Estate Center of the city of Vantaa and the studied school is greatly appreciated. Sweco Finland Oy (Sweco Asiantuntijapalvelut Oy) is acknowledged for conducting the indoor climate and structural investigations. László Kredics was supported by grant GINOP-2.3.2-15-2016-00012 (Széchenyi 2020 Programme, Hungary) and the János Bolyai Research Scholarship (Hungarian Academy of Sciences).
Author Contributions
Camilla Vornanen-Winqvist wrote the paper and conceived, designed, and performed every experiment; Kati Järvi analyzed the questionnaire data; Sander Toomla conceived, designed, and performed the ventilation experiments and contributed the measurement devices; Kaiser Ahmed designed and performed the ventilation experiments; Maria A. Andersson conceived, designed, and performed the mycobiota experiments, analyzed the data, and participated in writing the paper; Raimo Mikkola designed the IAQ experiments, contributed measurement devices, and analyzed the VOC samples; Tamás Marik and László Kredics designed and performed the identification of the fungal morphotypes; Heidi Salonen was responsible for designing and conceiving the IAQ experiments and questionnaires; Jarek Kurnitski was the principal investigator responsible for the study design.
Conflicts of Interest
The authors declare no conflict of interest. The founding sponsors had no role in the design of the study; in the collection, analyses, or interpretation of data; in the writing of the manuscript, and in the decision to publish the results.
Abbreviations
The following abbreviations are used in this manuscript:
| IAQ | Indoor air quality |
| TVOC | Total volatile organic compounds |
| PM2.5 | Fine particulate matter, particle size 2.5 μm |
| RH | Relative humidity |
| VOC | Volatile organic compounds |
| T | Temperature |
| CO2 | Carbon dioxide |
| CO | Carbon monoxide |
| FIOH | Finnish Institute of Occupational Health |
| MEA | Malt extract agar |
| 2E1H | 2-ethyl-1-hexanol |
References
- Haverinen-Shaughnessy, U.; Hyvärinen, A.; Putus, T.; Nevalainen, A. Monitoring success of remediation: seven case studies of moisture and mold damaged buildings. Sci. Total Environ. 2008, 399, 19–27. [Google Scholar] [CrossRef] [PubMed]
- Seppänen, O.A.; Fisk, W.J. Summary of human responses to ventilation. Indoor Air 2004, 14, 102–118. [Google Scholar] [CrossRef] [PubMed]
- Airaksinen, M.; Kurnitski, J.; Pasanen, P.; Seppänen, O. Fungal spore transport through a building structure. Indoor Air 2004, 14, 92–104. [Google Scholar] [CrossRef] [PubMed]
- Airaksinen, M.; Pasanen, P.; Kurnitski, J.; Seppänen, O. Microbial contamination of indoor air due to leakages from crawl space: A field study. Indoor Air 2004, 14, 55–64. [Google Scholar] [CrossRef] [PubMed]
- Meklin, T.; Putus, T.; Pekkanen, J.; Hyvärinen, A.; Hirvonen, M.-R.; Nevalainen, A. Effects of moisture-damage repairs on microbial exposure and symptoms in schoolchildren. Indoor Air 2005, 15, 40–47. [Google Scholar] [CrossRef] [PubMed]
- Wargocki, P.; Sundell, J.; Bischof, W.; Brundrett, G.; Fanger, P.O.; Gyntelberg, F.; Hanssen, S.O.; Harrison, P.; Pickering, A.; Seppänen, O.; et al. Ventilation and health in non-industrial indoor environments: report from a european multidisciplinary scientific consensus meeting (EUROVEN). Indoor Air 2002, 12, 113–128. [Google Scholar] [CrossRef] [PubMed]
- Bayer, C.W.; Grimes, C. The indoor environmental microbiome. Indoor Built Environ. 2015, 24, 1035–1037. [Google Scholar] [CrossRef]
- Cabral, J.P.S. Can we use indoor fungi as bioindicators of indoor air quality? Historical perspectives and open questions. Sci. Total Environ. 2010, 408, 4285–4295. [Google Scholar] [CrossRef] [PubMed]
- Fang, L.; Wyon, D.P.; Clausen, G.; Fanger, P.O. Impact of indoor air temperature and humidity in an office on perceived air quality, SBS symptoms and performance. Indoor Air 2004, 14, 74–81. [Google Scholar] [CrossRef] [PubMed]
- Wargocki, P.; Wyon, D.P.; Sundell, J.; Clausen, G.; Fanger, P.O. The effects of outdoor air supply rate in an office on perceived air quality, sick building syndrome (SBS) symptoms and productivity. Indoor Air 2000, 10, 222–236. [Google Scholar] [CrossRef] [PubMed]
- Carrer, P.; Wargocki, P.; Fanetti, A.; Bischof, W.; Fernandes, E.D.O.; Hartmann, T.; Kephalopoulos, S.; Palkonen, S.; Seppänen, O. What does the scientific literature tell us about the ventilation–health relationship in public and residential buildings? Build. Environ. 2015, 94, 273–286. [Google Scholar] [CrossRef]
- Kalamees, T. Measured and simulated air pressure conditions in finnish residential buildings. Build. Serv. Eng. Res. Technol. 2010, 31, 177. [Google Scholar] [CrossRef]
- Leivo, V.; Kiviste, M.; Aaltonen, A.; Turunen, M.; Haverinen-Shaughnessy, U. Air pressure difference between indoor and outdoor or staircase in multi-family buildings with exhaust ventilation system in Finland. Energy Procedia 2015, 78, 1218–1223. [Google Scholar] [CrossRef]
- Finnish Ministry of the Environment, Department of Built Environment. D2 National Building Code of Finland. Indoor Climate and Ventilation of the Buildings. Regulations and Guidelines; Finnish Ministry of the Environment, Department of Built Environment: Helsinki, Finland, 2012.
- Sweco Finland Oy. An Indoor Climate and Structural Investigation, Investigation Report); Sweco Asiantuntijapalvelut Oy (Sweco Finland Oy): Helsinki, Finland, 2016. [Google Scholar]
- The Finnish Institute of Occupational Health. Summary of the Levels of Indoor Air Pollutants and Conditions that can Refer to Indoor Environment Problems; The Finnish Institute of Occupational Health: Helsinki, Finland, 2017. [Google Scholar]
- ISO 16000-6 Standard. Indoor Air—Part 6: Determination of Volatile Organic Compounds in Indoor and Test Chamber Air by Active Sampling on Tenax TA Sorbent, Thermal Desorption and Gas Chromatography Using MS or MS-FID; International Organization for Standardization (ISO): Geneva, Switzerland, 2011. [Google Scholar]
- Andersson, M.A.; Jääskeläinen, E.L.; Shaheen, R.; Pirhonen, T.; Wijnands, L.M.; Salkinoja-Salonen, M.S. Sperm bioassay for rapid detection of cereulide-producing bacillus cereus in food and related environments. Int. J. Food Microbiol. 2004, 94, 175–183. [Google Scholar] [CrossRef] [PubMed]
- Bencsik, O.; Papp, T.; Berta, M.; Zana, A.; Forgó, P.; Dombi, G.; Andersson, M.A.; Salkinoja-Salonen, M.; Vágvölgyi, C.; Szekeres, A. Ophiobolin a from bipolaris oryzae perturbs motility and membrane integrities of porcine sperm and induces cell death on mammalian somatic cell lines. Toxins 2014, 6, 2857–2871. [Google Scholar] [CrossRef] [PubMed]
- Samson, R.A.; Hoekstra, E.S.; Frisvad, J.C. Introduction to Food-and Airborne Fungi; Centraalbureau voor Schimmelcultures (CBS): Utrecht, The Netherlands, 2004. [Google Scholar]
- Andersson, M.A.; Mikkola, R.; Raulio, M.; Kredics, L.; Maijala, P.; Salkinoja-Salonen, M.S. Acrebol, a novel toxic peptaibol produced by an acremonium exuviarum indoor isolate. J. Appl. Microbiol. 2009, 106, 909–923. [Google Scholar] [CrossRef] [PubMed]
- Andersson, K. Epidemiological approach to indoor air problems. Indoor Air 1998, 8, 32. [Google Scholar] [CrossRef]
- Mattila, M.; Vornanen-Winqvist, C.; Jerkku, I.; Kurnitski, J. The effect of positive pressure and air tighntess on the moistural behavior of buildings. In The Building Physics Conference 24 October 2017–26 October 2017, Conference Publication 4; Tampere University of Technology: Tampere, Finland, 2017; pp. 91–93. [Google Scholar]
- Finnish Society of Indoor Air Quality and Climate (FiSIAQ). Classification of Indoor Air Environment 2008. Target Values, Design Guidance and Product Requirements; FiSIAQ: Espoo, Finland, 2008. [Google Scholar]
- Azuma, K. Evaluating prevalence and risk factors of building-related symptoms among office workers: Seasonal characteristics of symptoms and psychosocial and physical environmental factors. Environ. Health 2017, 22, 38. [Google Scholar] [CrossRef] [PubMed]
- Haghighat, F.; De Bellis, L. Material emission rates: Literature review, and the impact of indoor air temperature and relative humidity. Build. Environ. 1998, 33, 261–277. [Google Scholar] [CrossRef]
- Wolkoff, P. Impact of air velocity, temperature, humidity, and air on long-term voc emissions from building products. Atmos. Environ. 1998, 32, 2659–2668. [Google Scholar] [CrossRef]
- Fang, L. Impact of temperature and humidity on the perception of indoor air quality. Indoor Air 1998, 8, 80. [Google Scholar] [CrossRef]
- Ministry of Social Affairs and Health. Decree of the Ministry of Social Affairs and Health on Health-Related Conditions of Housing and Other Residential Buildings and Qualification Requirements for Third-Party Experts (545/2015); Ministry of Social Affairs and Health: Helsinki, Finland, 2015.
- Reijula, K.; Sundman Digert, C. Assessment of indoor air problems at work with a questionnaire. Occup. Environ. Med. 2004, 61, 33–38. [Google Scholar] [PubMed]
- Lahtinen, M.; Sundman Digert, C.; Reijula, K. Psychosocial work environment and indoor air problems: A questionnaire as a means of problem diagnosis. Occup. Environ. Med. 2004, 61, 143–149. [Google Scholar] [CrossRef] [PubMed]
- Hellgren, U.M. Complaints and symptoms among hospital staff in relation to indoor air and the condition and need for repairs in hospital buildings. Scand. J. Work Environ. Health 2008, 34, 58. [Google Scholar]
- Jaakkola, J.J.; Heinoneon, O.P.; Seppänen, O. Mechanical ventilation in office buildings and the sick building syndrome: An experimental and epidemiological study. Indoor Air 1991, 1, 111–121. [Google Scholar] [CrossRef]
- Paulussen, C.; Hallsworth, J.E.; Álvarez-Pérez, S.; Nierman, W.C.; Hamill, P.G.; Blain, D.; Rediers, H.; Lievens, B. Ecology of Aspergillosis: Insights into the pathogenic potency of Aspergillus fumigatus and some other Aspergillus species. Microb. Biotechnol. 2017, 10, 296–322. [Google Scholar] [CrossRef] [PubMed]
© 2018 by the authors. Licensee MDPI, Basel, Switzerland. This article is an open access article distributed under the terms and conditions of the Creative Commons Attribution (CC BY) license (http://creativecommons.org/licenses/by/4.0/).











